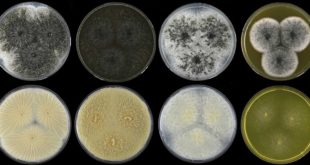

Nový druh škodlivé houby byl objeven pod kůrou kmene ořešáku královského nedaleko Brna. Houba je aktivně šířena nepůvodním kůrovcem, který se na ořešácích v Evropě vyskytuje posledních 15 let. Vědci potvrdili, že tato houba dokáže působit závažná oslabení a poškození stromů. Výsledky studie využijí instituce zabývající se ochranou rostlin a …
Read More »Vědci objevili nové druhy vzácných hub. Dovedla je k tomu analýza arzénu
Pod označením jarní houby baňky velkokališné se skrývá nejméně jedenáct samostatných druhů. Zjistili to vědci z Ústavu jaderné fyziky AV ČR, Geologického ústavu AV ČR a Mikrobiologického ústavu AV ČR ve spolupráci s dalšími výzkumnými institucemi a amatérskými mykology z Česka a USA. Objevu nových hub, z nichž dva druhy …
Read More »Asteroid, který vyhubil dinosaury, mohl současně odstartovat zemědělství mravenců
Nejenom konec (neptačích) dinosaurů a uvolnění cesty savcům, ale také řadu dalších dopadů měl dopad asteroidu na konci křídy. Možná včetně první neolitické revoluce. Samotný původ mravenců pěstujících houby (fylogeneze, zařazení do další mravenčí systematiky) byl již znám poměrně dobře, ale chyběly konkrétnější časové údaje. Spoluautor nové studie André Rodrigues …
Read More »Čeští vědci se podílejí na vytvoření genové databáze ohrožených druhů hub
Evropským vědcům se podařilo vytvořit databázi genomů 98 ohrožených živočichů, rostlin a hub. Konsorcium Evropský referenční genomový atlas hlásí úspěch svého pilotního projektu. Tato průkopnická iniciativa shromáždila rozsáhlou síť spolupracujících výzkumných pracovníků a institucí z 33 evropských zemí za účelem vytvořit vysoce kvalitní genomy 98 evropských druhů vyšších organismů. Jde …
Read More »Vědci synteticky připravili meroterpenoid, který obsahuje houba využívaná v čínské medicíně
Ganoapplanin vykazuje inhibující aktivitu vůči CaV3 iontového kanálu, který hraje důležitou roli zejména pro funkci srdce a mozku. Vědci z Univerzity Innsbruck, mezi kterými byl i Ondřej Kováč z katedry organické chemie Přírodovědecké fakulty Univerzity Palackého v Olomouci, jako první na světě pomocí nové metody synteticky připravili složitou chemickou látku …
Read More »Amatérský mykolog našel na Pálavě vzácnou houbu, která dosud rostla jen v USA
Unikátní podzemní houbu objevil amatérský mykolog na Milovické stráni v CHKO Pálava. Ve spolupráci s vědci z Mikrobiologického ústavu AV ČR ji identifikoval jako sesličku poduškovitou. Ta je přitom známá pouze z horských lesů na západě Spojených států a patří mezi vzácné a chráněné druhy. V Evropě se našla vůbec …
Read More »Houbu objevenou v plících pacienta pojmenovali po českém vědci
Mezinárodní tým mykologů z Nizozemí a Iránu objevil u íránského pacienta s dýchacími problémy nový druh houby způsobující plicní onemocnění. Pojmenovali ji Aspergillus hubkae jako výraz ocenění za dlouhodobou práci českého vědce Víta Hubky (38 let) z Mikrobiologického ústavu AV ČR. V historii české vědy bylo takto mladému výzkumníkovi uděleno …
Read More »Neznámé houby, pomocník i hrozba
Všudypřítomné houby se hojně využívají v potravinářství, v biotechnologiích i medicíně. Přesto je většina z nich neznámá. Důkladně zmapovaný není ani jejich léčivý potenciál, stejně jako rizika pro lidské zdraví či životní prostředí. Nově je bude studovat interdisciplinární tým v programu Houby – nové hrozby i příležitosti (MycoLife – svět …
Read More »K čemu je houbám psilocybin? Možná byl proti plžům – po konci dinosaurů
Houby z rodu Psilocybe (i některých dalších) nevytvářejí psychoaktivní látky psilocybin a psilocyn proto, aby nám poskytly rekreační halucinogeny ani nová antidepresiva. Význam těchto sloučenin pro samotné houby ovšem zatím neznáme, nebo si alespoň nejsme jisti. Nová studie naznačuje možné odpovědi díky výzkumu evoluce těchto molekul. Tým pod vedením vědců …
Read More »Největší světová databáze mykorhizních hub může zodpovědět mnoho otázek
Téměř 8500 vzorků a více než 50 milionů pozorování zahrnuje největší světová databáze arbuskulárně mykorhizních hub – tedy mikroskopických hub, které prorůstají kořeny cévnatých rostlin a navzájem si pomáhají. Zveřejnili ji vědci z Mikrobiologického ústavu AV ČR a Přírodovědecké fakulty Univerzity Karlovy. Data z GlobalAMFungi databáze pomohou zodpovědět důležité otázky …
Read More » Sciencemag.cz
Sciencemag.cz